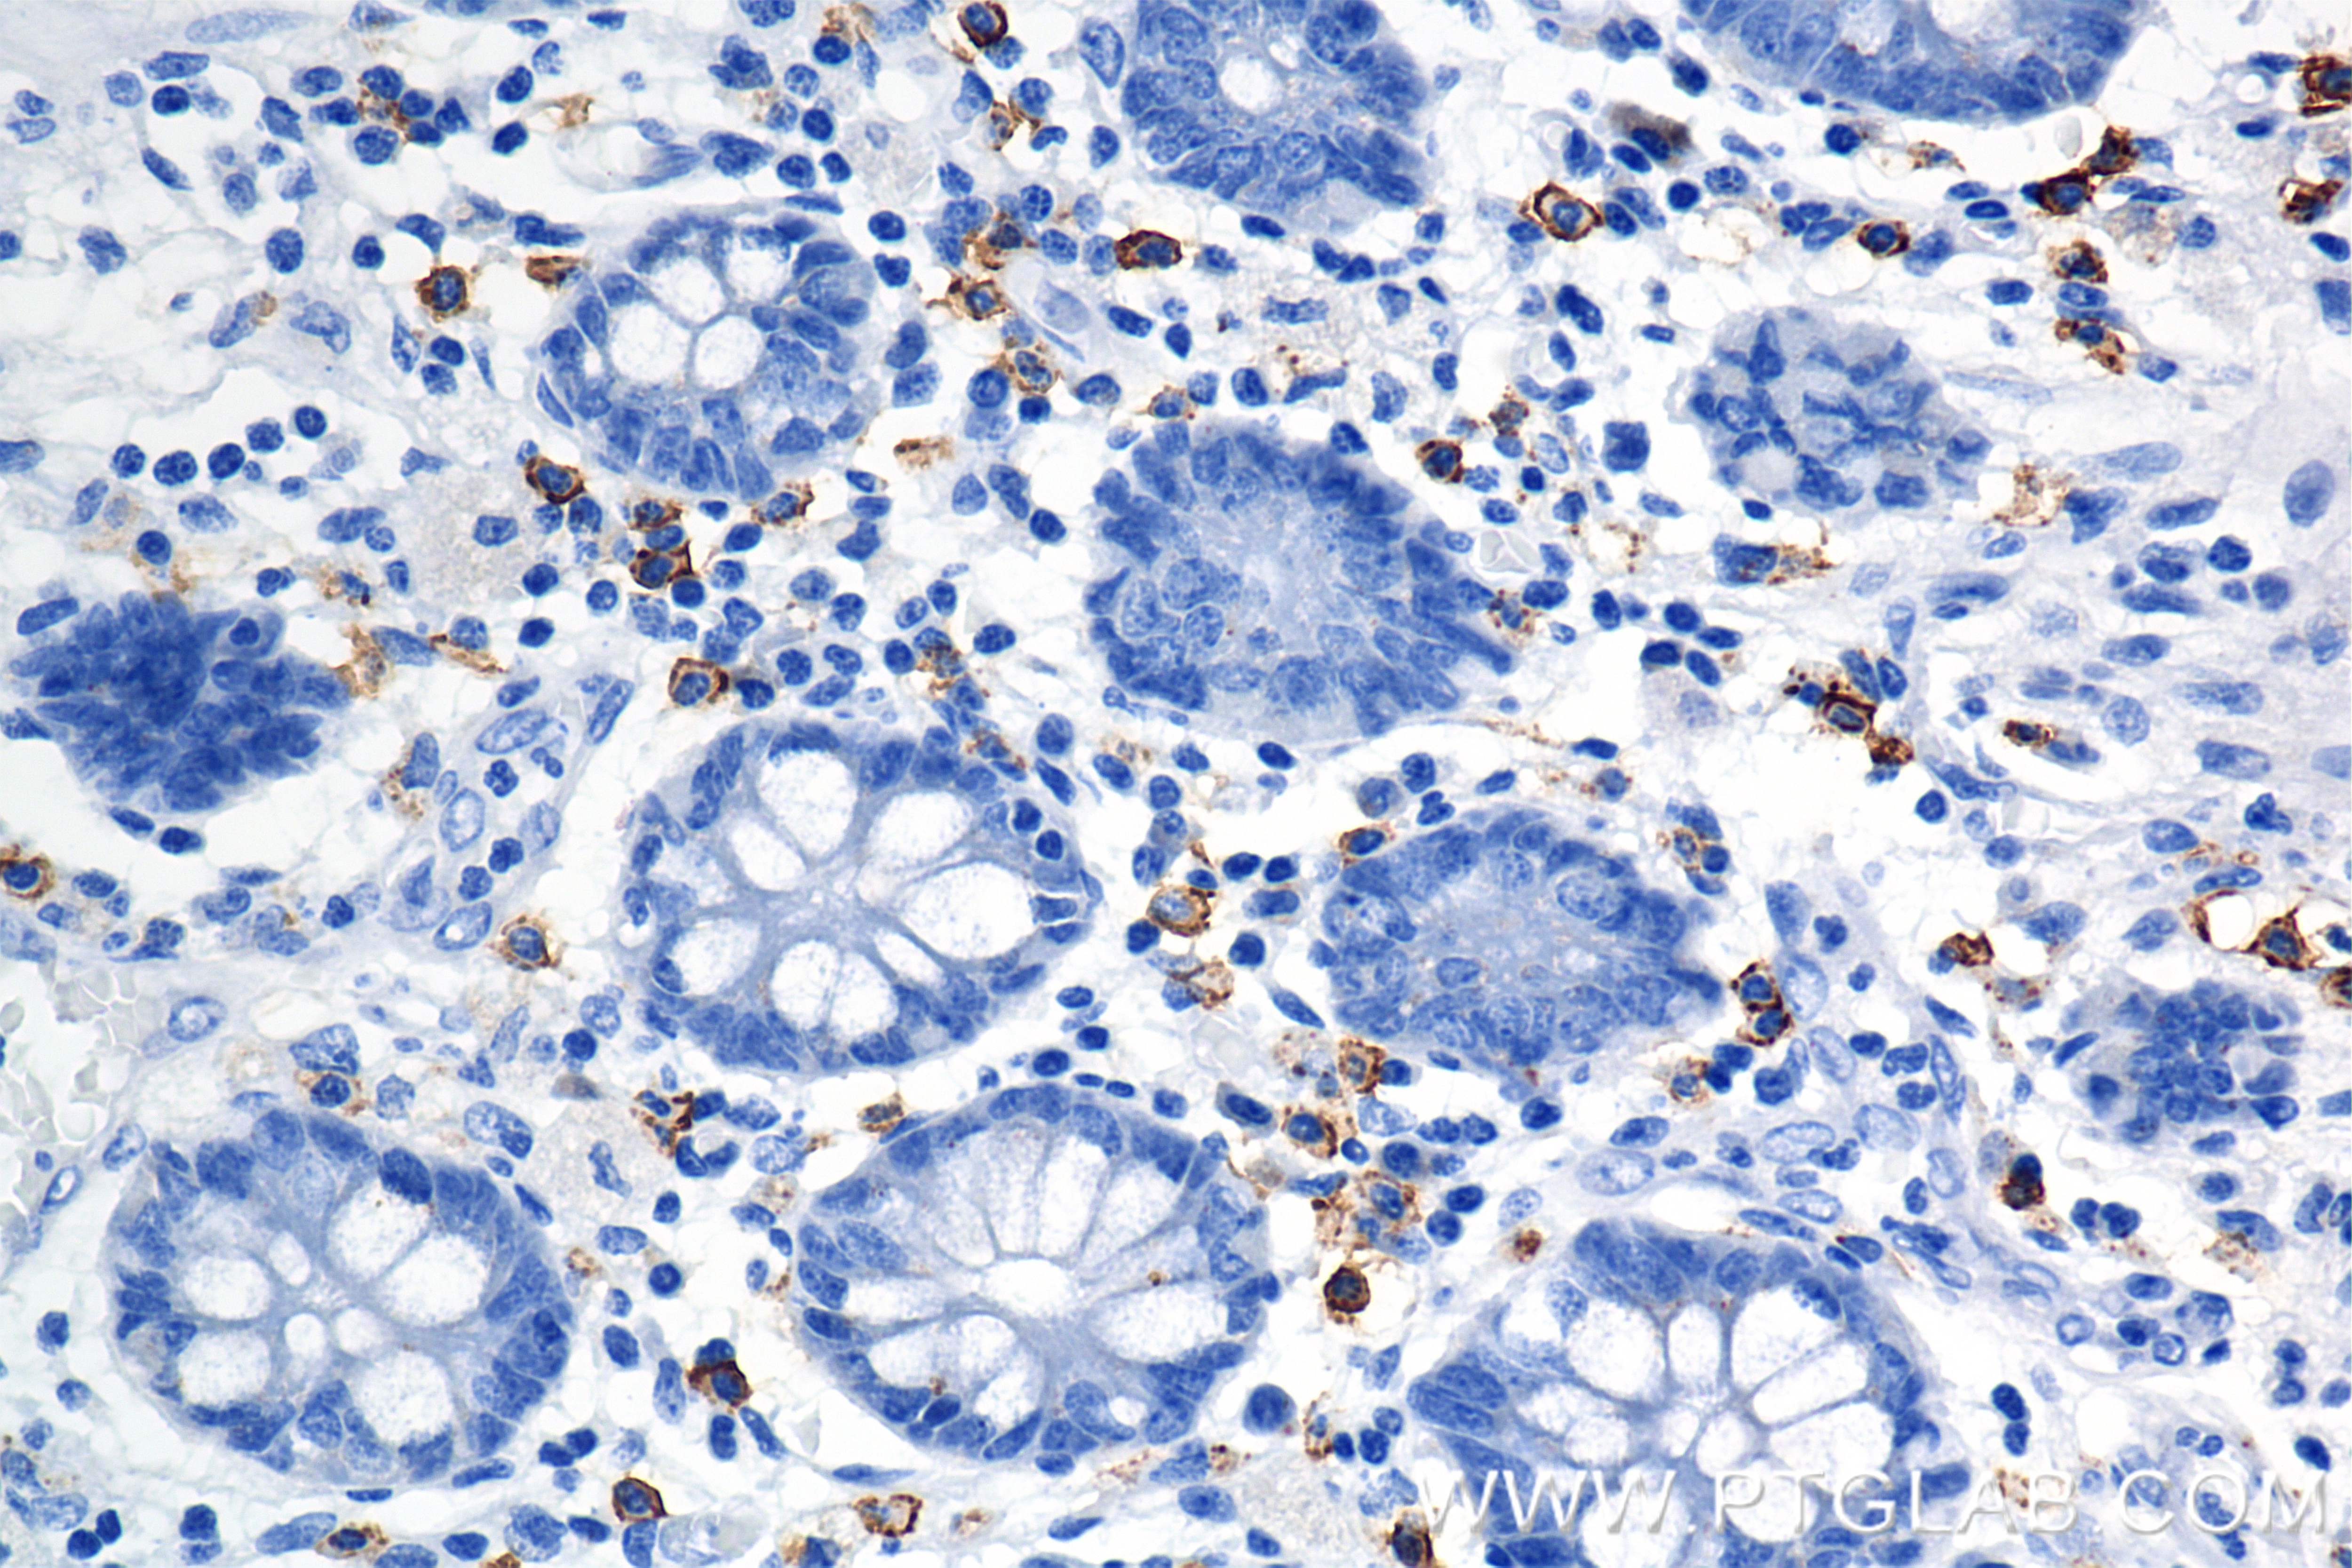
Immunohistochemical analysis of paraffin-embedded human colon tissue slide using 84259-10-RR (C-Kit antibody) at dilution of 1:5000 (under 40x lens). Heat mediated antigen retrieval with Sodium Citrate buffer (pH 6.0). Immunohistochemistry (IHC) staining of human colon tissue using CD117/c-Kit Recombinant antibody (84259-10-RR)
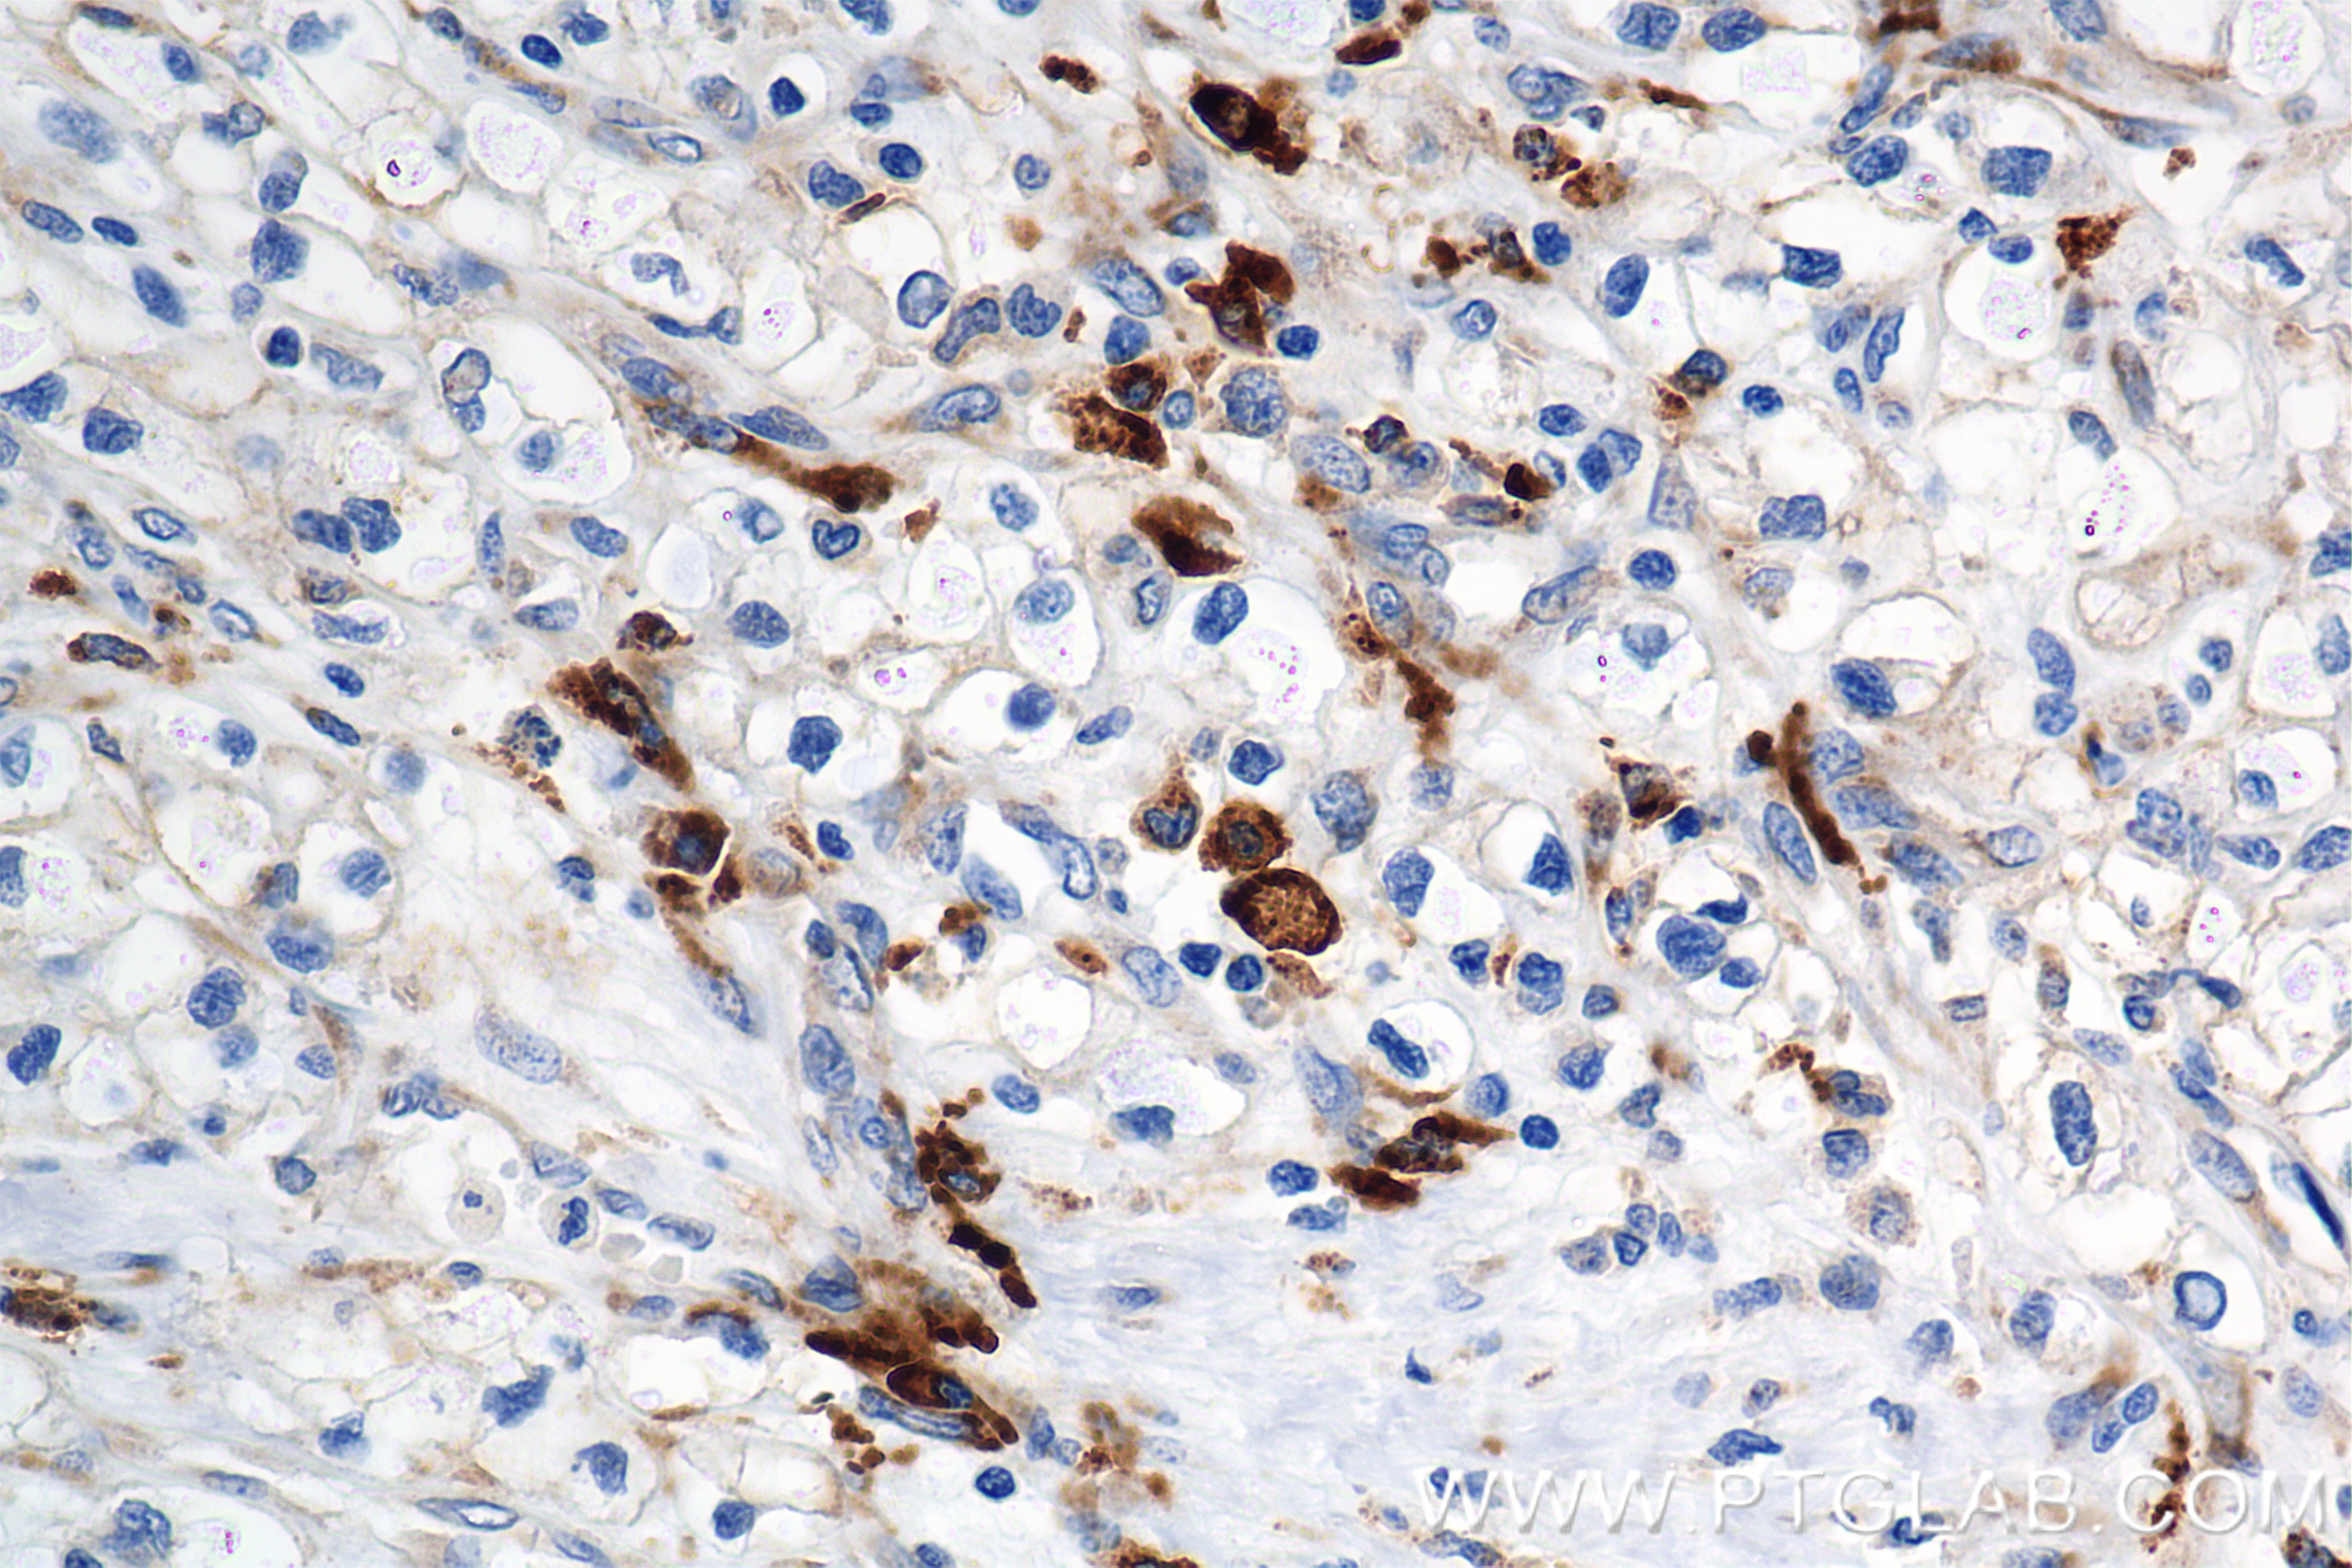
Immunohistochemical analysis of paraffin-embedded Human Kidney(renal cell) Cancer slide using 84259-10-RR (C-Kit antibody) at dilution of 1:1000 (under 40x lens). Heat mediated antigen retrieval with Tris-EDTA buffer (pH 9.0). Immunohistochemistry (IHC) staining of Human Kidney(renal cell) Cancer using CD117/c-Kit Recombinant antibody (84259-10-RR)

Validation Data Gallery
Tested Applications
| Positive IHC detected in | human colon tissue, human gastrointestinal stromal tumor tissue, human kidney (renal cell) cancer Note: suggested antigen retrieval with TE buffer pH 9.0; (*) Alternatively, antigen retrieval may be performed with citrate buffer pH 6.0 |
| Positive IF/ICC detected in | Kasumi-1 cells |
Recommended dilution
| Application | Dilution |
|---|---|
| Immunohistochemistry (IHC) | IHC : 1:2500-1:10000 |
| Immunofluorescence (IF)/ICC | IF/ICC : 1:250-1:1000 |
| It is recommended that this reagent should be titrated in each testing system to obtain optimal results. | |
| Sample-dependent, Check data in validation data gallery. | |
Product Information
84259-10-RR targets CD117/c-Kit in IHC, IF/ICC, ELISA applications and shows reactivity with human samples.
| Tested Reactivity | human |
| Host / Isotype | Rabbit / IgG |
| Class | Recombinant |
| Type | Antibody |
| Immunogen |
Recombinant protein 相同性解析による交差性が予測される生物種 |
| Full Name | v-kit Hardy-Zuckerman 4 feline sarcoma viral oncogene homolog |
| Calculated molecular weight | 976 aa, 110 kDa |
| GenBank accession number | BC071593 |
| Gene Symbol | CD117 |
| Gene ID (NCBI) | 3815 |
| Conjugate | Unconjugated |
| Form | |
| Form | Liquid |
| Purification Method | Protein A purification |
| UNIPROT ID | P10721 |
| Storage Buffer | PBS with 0.02% sodium azide and 50% glycerol{{ptg:BufferTemp}}7.3 |
| Storage Conditions | Store at -20°C. Stable for one year after shipment. Aliquoting is unnecessary for -20oC storage. |
Background Information
CD117, also known as c-Kit and SCFR, is a transmembrane protein with tyrosine kinase activity encoded by the oncogene c-kit (PMID: 2448137). It is a member of the type III receptor tyrosine kinase family, which also includes CSF-1R, PDGFRβ, PDGFRα, and FLT3 (PMID: 29518044). CD117 is expressed on hematopoietic stem cells and progenitor cells, mast cells, and is also found in a wide range of non-haemopoietic cell types (including melanocytes, germ cells, astrocytes, renal tubules, breast glandular epithelial cells, sweat glands, and interstitial cells of Cajal) (PMID: 10582338; 23073628). CD117 plays an important role in early hemopoiesis. It is also involved in pigmentation, fertility, gut movement, and some aspects of the nervous system (PMID: 23073628).
Protocols
| Product Specific Protocols | |
|---|---|
| IF protocol for CD117/c-Kit antibody 84259-10-RR | Download protocol |
| IHC protocol for CD117/c-Kit antibody 84259-10-RR | Download protocol |
| Standard Protocols | |
|---|---|
| Click here to view our Standard Protocols |